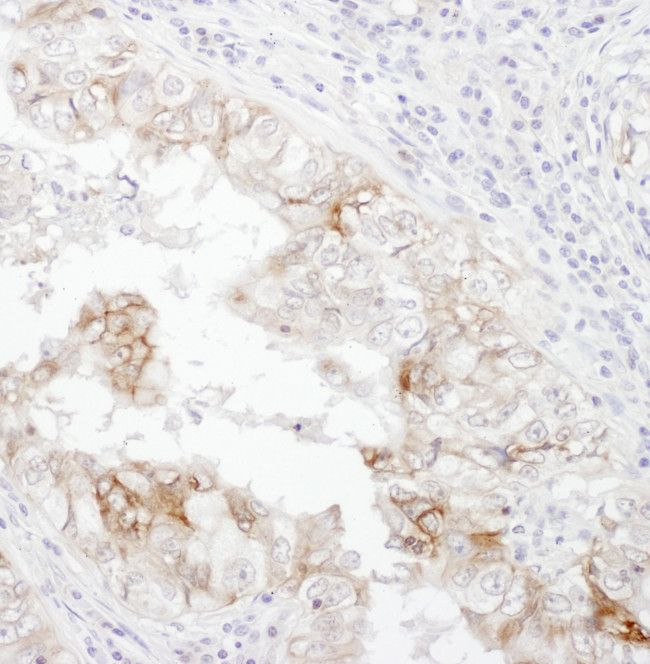
CD98 Antibody in Immunohistochemistry (Paraffin) (IHC (P))

Search
Bethyl Laboratories
CD98 Polyclonal Antibody
{{$productOrderCtrl.translations['antibody.pdp.commerceCard.promotion.promotions']}}
{{$productOrderCtrl.translations['antibody.pdp.commerceCard.promotion.viewpromo']}}
{{$productOrderCtrl.translations['antibody.pdp.commerceCard.promotion.promocode']}}: {{promo.promoCode}} {{promo.promoTitle}} {{promo.promoDescription}}. {{$productOrderCtrl.translations['antibody.pdp.commerceCard.promotion.learnmore']}}
图: 1 / 2
CD98 Antibody (A304-331A) in IHC (P)


Please note: We are reviewing Western blot images included in the antibody testing data in our catalog, including those provided by third parties. Unless expressly labeled or annotated as “raw-unedited”, Western blot images included in the antibody testing data in our catalog may have been edited, optimized or otherwise adjusted for presentation.
产品信息
A304-331A
种属反应
宿主/亚型
分类
类型
抗原
偶联物
形式
浓度
规格
纯化类型
保存液
内含物
保存条件
运输条件
产品详细信息
The recommended shelf life for this product is 1 year from date of receipt.
Application Note: For IHC, epitope retrieval with citrate buffer pH 6.0 is recommended for FFPE tissue sections.
靶标信息
CD98 (4F2) is a type II transmembrane glycoprotein which serves as the heavy chain of the heterodimeric amino acid transporters (HATs). CD98, linked to various light chains by disulfide bond, is responsible for cell surface expression and basolateral localization of this transporter complex in polarized epithelial cells and also interacts with beta1 integrins and increases their affinity for ligand. Besides its roles in amino acid transport, CD98 is thus involved in cell fusion and activation. It is implicated in regulation of cellular differentiation, growth and apoptosis.
仅用于科研。不用于诊断过程。未经明确授权不得转售。
篇参考文献 (0)
生物信息学
蛋白别名: 4F2 cell-surface antigen heavy chain; 4F2 heavy chain antigen; 4F2hc; Amino acid transporter heavy chain SLC3A2; CD98; Lymphocyte activation antigen 4F2 large subunit; Solute carrier family 3 member 2
基因别名: MDU1; SLC3A2
Entrez Gene ID: (Human) 6520